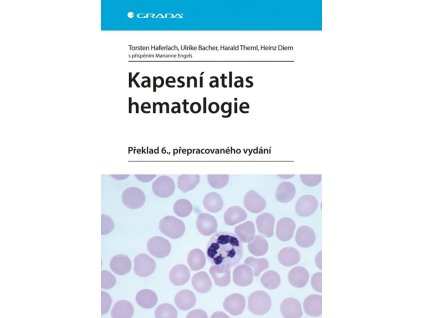
97568 kapesni atlas hematologie

Soudní sexuologie

Dárek zdarma
Ke každé objednávce

Doprava zdarma
nad 700 Kč

Věrnostní program
Zaregistujte se!

Prodejna v centru Liberce
Navštivte nás!
Související produkty
Detailní popis produktu
Publikace známého českého sexuologa mapuje oblast lidské sexuální patologie, která se odráží v trestněprávních a občanskoprávních vztazích.Jejím cílem je představit pravidla, praxi i současný právní rámec odborné expertizy, především v okruhu sexuálně motivovaných trestných činů. V souladu s mezinárodně uznaným vymezením pojmů v 11. revizi Mezinárodní klasifikace nemocí (MKN-11) zavádí novou terminologii u stavů souvisejících se sexuálním zdravím a u parafilních poruch. Některé anomálie sexuálně motivačního systému jsou osvětleny názornými kazuistikami. Monografie dále shrnuje aktuální poznatky o dopadu soudně nařízených ochranných opatření na kriminální recidivitu pachatelů.
Kniha směřuje nejen ke čtenářům z řad lékařů a psychologů, ale i k právníkům, kriminalistům, probačním úředníkům a sociálním pracovníkům. Může být podnětem pro rozšíření znalecké erudice, růst potřebné empatie a snazší mezioborové dorozumění.
Doplňkové parametry
| Kategorie: | Lékařská literatura |
|---|---|
| Hmotnost: | 0.48 kg |
| EAN: | 9788027151097 |
| Autor: | Brichcín Slavoj |
| Rok vydání: | 2025 |
| Nakladatel: | GRADA Publishing, a. s. |
| Vazba: | Brožovaná |
| Počet stran: | 280 |
| Položka byla vyprodána… | |
Hodnocení produktu
Buďte první, kdo napíše příspěvek k této položce.
Diskuze
Buďte první, kdo napíše příspěvek k této položce.